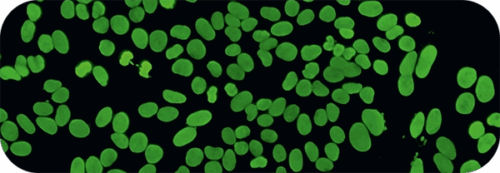
1983_web

Euroimmun’s journey began in 1979 with the development of our TITERPLANE® technology, a process that helped standardize immunofluorescence testing by ensuring precise and uniform incubation. Over the following decades, Euroimmun introduced innovative advancements, from BIOCHIP mosaic technology and automated microscopy with EUROPattern to comprehensive ELISA and ChLIA platforms, each setting new benchmarks in precision and efficiency. In 2022, the launch of the UNIQO 160 marked another major milestone in Euroimmun’s evolution, advancing toward fully automated, walkaway IFA (Indirect Immunofluorescence Assay) processing and reinforcing our ongoing commitment to innovation in laboratory diagnostics.

Invention of TITERPLANE technique optimized incubation conditions for IFA

BIOCHIP technology revolutionizes IFA
Founding of EUROIMMUN


First ELISA: Anti-M2 ELISA (Anti-mitochondrial antibodies)
First infectious diseases ELISA: Anti-Borrelia ELISA


EUROPLUS Technology: Multiplex IFA by combining tissue and antigen spots
Anti-CCP ELISA: Breakthrough in rheumatoid arthritis diagnostics


Anti-Borrelia plus VlsE ELISA (IgG): First assay based on recombinant antigen
Analyzer I: First laboratory device


Designer Antigens: Anti-Gliadin (GAF-3X) ELISA with gliadin-analogous fusion peptide
EUROLabOffice: Laboratory Information System
Anti-NMDAR IFA: First recombinant cell (RC) IFA
Nucleosome-mediated coupling of nDNA to the surface of ELISA wells (dsDNA-NcX)


BIOCHIP Mosaics with recombinant cell substances
EUROPattern Microscope: First automated microscope
IFA Automation: Sprinter XL and IF Sprinter


EUROBlotOne: Fully Automated blot device
Milestone in diagnostics of membranous nephropathy: Exclusive anti-phospholipase A2 receptor (PLA2R) assays
Identification of allergy-inducing Components using defined partial allergen diagnostics (DPA-Dx)
EUROArrayScanner


Anti-Zika virus ELISA: Worldwide first CE-marked IVD test
IFA slide washer: MERGITE!
EURLabWorkstation ELISA: Euroimmun’s high-throughput solution for fully automated ELISA processing


EUROArray dermatomycosis: New standard in diagnostics of fungal infections of the skin
EUROLabWorkstation IFA
RA Analyzer 10: First random access device based on ChLIA technology


EURORealTime SARS-CoV-2 and Anti-SARS-CoV-2 ELISA among the first CE-marked assays in Europe for COVID-19 diagnostics
Immunodiagnostic Systems Holding (IDS) was acquired by Revvity, Inc., joining Euroimmun within “Clinical & Diagnostics”.


A breakthrough in IFA automation, the UNIQO 160 integrates every step, from primary sample pipetting to automated IFA image acquisition, into a single, fully automated instrument.
Euroimmun introduces Pattern IQ, an interactive immunofluorescence assay (IFA) training platform that helps laboratory professionals strengthen their pattern recognition skills through education, practice, and assessment.


Euroimmun rebranding – A new design with a new shine
2026 Euroimmun US
Privacy Policy | Website Terms and Conditions | Cookie Notice and Settings | Consent Preferences | Sitemap